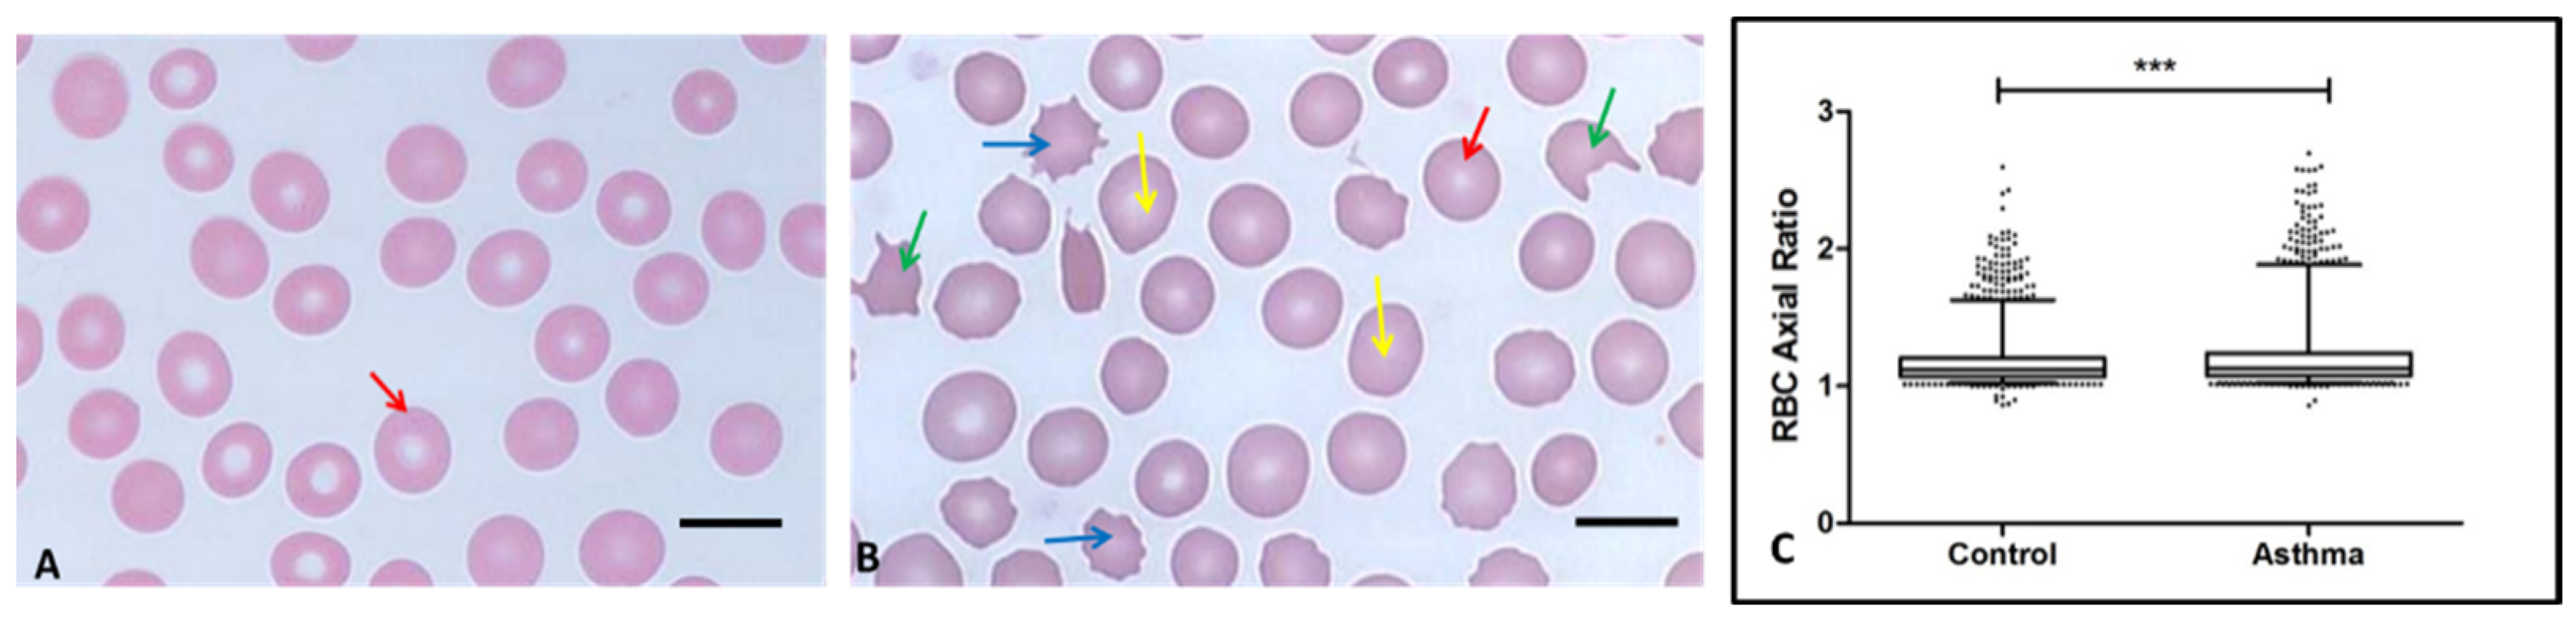
Hemato 04 00009 g001 Hemato 04 00009 g001

Scanning Electron and Atomic Force Microscopic Analysis of Erythrocytes in a Cohort of Atopic Asthma Patients—A Pilot Study
Abstract
1. Background
2. Study Design and Methods
2.1. Patient Recruitment
- 30 healthy individuals (control group)
- 30 patients (experimental group) diagnosed with atopic asthma from Steve Biko Academic Hospital, Lung Unit, South Africa.
2.2. Blood Sample Collection
2.3. Methods
2.3.1. Light Microscopy
2.3.2. Atomic Force Microscopy
2.3.3. Statistical Analysis of AFM Data
2.3.4. Preparation of Blood Pellet for Scanning Electron Microscopy
2.3.5. Statistical Analysis
3. Results
3.1. Patient Demographics and Biochemical Parameters
3.2. Haematology Analysis
3.3. Light Microscopy and Axial Ratio
3.4. Atomic Force Microscopy on Erythrocyte Membrane Elasticity
3.5. Scanning Electron Microscopy Analysis of Erythrocyte Ultrastructure
4. Discussion
5. Conclusions
6. Study Limitations
Author Contributions
Funding
Institutional Review Board Statement
Informed Consent Statement
Data Availability Statement
Acknowledgments
Conflicts of Interest
Ethics Approval and Consent to Participate
Consent for Publication
References
- Lundbäck, B.; Backman, H.; Lötvall, J.; Rönmark, E. Is asthma prevalence still increasing? Expert Rev. Respir. Med. 2016, 10, 39–51. [Google Scholar] [CrossRef] [PubMed]
- Diseases, G.B.D.; Injuries, C. Global burden of 369 diseases and injuries in 204 countries and territories, 1990-2019: A systematic analysis for the Global Burden of Disease Study 2019. Lancet 2020, 396, 1204–1222. [Google Scholar] [CrossRef]
- Bruno, F.; Spaziano, G.; Liparulo, A.; Roviezzo, F.; Nabavi, S.M.; Sureda, A.; Filosa, R.; D’Agostino, B. Recent advances in the search for novel 5-lipoxygenase inhibitors for the treatment of asthma. Eur. J. Med. Chem. 2017, 114, 70–77. [Google Scholar] [CrossRef]
- Mwanga, H.H.; Baatjies, R.; Singh, T.; Jeebhay, M.F. Work-related allergy and asthma associated with cleaning agents in health workers in Southern African tertiary hospitals. Am. J. Ind. Med. 2022, 65, 382–395. [Google Scholar] [CrossRef]
- Saglani, S.; Lloyd, C.M. Novel concepts in airway inflammation and remodelling in asthma. Eur. Respir. J. 2015, 46, 1796–1804. [Google Scholar] [CrossRef]
- Bergeron, C.; Tulic, M.K.; Hamid, Q. Airway remodelling in asthma: From benchside to clinical practice. Can. Respir. J. 2010, 17, e85–e93. [Google Scholar] [CrossRef] [PubMed]
- Vercelli, D. Gene-environment interactions in asthma and allergy: The end of the beginning? Curr. Opin. Allergy Clin. Immunol. 2010, 10, 145–148. [Google Scholar] [CrossRef]
- Skadhauge, L.R.; Christensen, K.; Kyvik, K.O.; Sigsgaard, T. Genetic and environmental influence on asthma: A population-based study of 11,688 Danish twin pairs. Eur. Respir. J. 1999, 13, 8–14. [Google Scholar] [CrossRef] [PubMed]
- Koeppen-Schomerus, G.; Stevenson, J.; Plomin, R. Genes and environment in asthma: A study of 4 year old twins. Arch. Dis. Child. 2001, 85, 398–400. [Google Scholar] [CrossRef] [PubMed]
- Ober, C.; Yao, T.C. The genetics of asthma and allergic disease: A 21st century perspective. Immunol. Rev. 2011, 242, 10–30. [Google Scholar] [CrossRef]
- Feleszko, W.; Ruszczynski, M.; Jaworska, J.; Strzelak, A.; Zalewski, B.M.; Kulus, M. Environmental tobacco smoke exposure and risk of allergic sensitisation in children: A systematic review and meta-analysis. Arch. Dis. Child. 2014, 99, 985–992. [Google Scholar] [CrossRef]
- Hallit, S.; Bou Assy, T.; Hallit, R.; Salameh, P. Allergic Diseases, Smoking and Environmental Exposure Among University Students in Lebanon. J. Asthma Off. J. Assoc. Care Asthma 2017, 55, 35–42. [Google Scholar] [CrossRef]
- Nelson, H.S. The importance of allergens in the development of asthma and the persistence of symptoms. Dis. Mon. DM 2001, 47, 5–15. [Google Scholar] [CrossRef] [PubMed]
- Kelly, F.J.; Mudway, I.S.; Fussell, J.C. Air Pollution and Asthma: Critical Targets for Effective Action. Pulm. Ther. 2021, 7, 9–24. [Google Scholar] [CrossRef] [PubMed]
- Regateiro, F.S.; Botelho Alves, P.; Moura, A.L.; Azevedo, J.P.; Regateiro, D.T. The diverse roles of T cell subsets in asthma. Eur. Ann. Allergy Clin. Immunol. 2021, 53, 201–208. [Google Scholar] [CrossRef] [PubMed]
- Han, X.; Krempski, J.W.; Nadeau, K. Advances and novel developments in mechanisms of allergic inflammation. Allergy 2020, 75, 3100–3111. [Google Scholar] [CrossRef]
- Ahmad, S.; Azid, N.A.; Boer, J.C.; Lim, J.; Chen, X.; Plebanski, M.; Mohamud, R. The key role of TNF-TNFR2 interactions in the modulation of allergic inflammation: A review. Front. Immunol. 2018, 9, 2572. [Google Scholar] [CrossRef]
- Moldoveanu, B.; Otmishi, P.; Jani, P.; Walker, J.; Sarmiento, X.; Guardiola, J.; Saad, M.; Yu, J. Inflammatory mechanisms in the lung. J. Inflamm. Res. 2009, 2, 1–11. [Google Scholar] [PubMed]
- Bester, J.; Pretorius, E. Effects of IL-1β, IL-6 and IL-8 on Erythrocytes, Platelets and Clot Viscoelasticity. Sci. Rep. 2016, 6, 32188. [Google Scholar] [CrossRef]
- Page, M.J.; Bester, J.; Pretorius, E. The inflammatory effects of TNF-α and complement component 3 on coagulation. Sci. Rep. 2018, 8, 1812. [Google Scholar] [CrossRef]
- Buys, A.V.; Van Rooy, M.J.; Soma, P.; Van Papendorp, D.; Lipinski, B.; Pretorius, E. Changes in red blood cell membrane structure in type 2 diabetes: A scanning electron and atomic force microscopy study. Cardiovasc. Diabetol. 2013, 12, 25. [Google Scholar] [CrossRef] [PubMed]
- Jeongho, K.; HoYoon, L.; Sehyun, S. Advances in the measurement of red blood cell deformability: A brief review. J. Cell. Biotechnol. 2015, 1, 63–79. [Google Scholar]
- AlMomani, T.D.; Vigmostad, S.C.; Chivukula, V.K.; Al-zube, L.; Smadi, O.; BaniHani, S. Red blood cell flow in the cardiovascular system: A fluid dynamics perspective. Crit. Rev. Biomed. Eng. 2012, 40, 427–440. [Google Scholar] [CrossRef]
- Pretorius, E.; Kell, D.B. Diagnostic morphology: Biophysical indicators for iron-driven inflammatory diseases. Integr. Biol. Quant. Biosci. Nano Macro 2014, 6, 486–510. [Google Scholar] [CrossRef] [PubMed]
- Dupire, J.; Socol, M.; Viallat, A. Full dynamics of a red blood cell in shear flow. Proc. Natl. Acad. Sci. USA 2012, 109, 20808–20813. [Google Scholar] [CrossRef]
- Zuk, A.; Targosz-Korecka, M.; Szymonski, M. Effect of selected drugs used in asthma treatment on morphology and elastic properties of red blood cells. Int. J. Nanomed. 2011, 6, 249–257. [Google Scholar] [CrossRef]
- Mohandas, N.; Chasis, J.A. Red blood cell deformability, membrane material properties and shape: Regulation by transmembrane, skeletal and cytosolic proteins and lipids. Semin. Hematol. 1993, 30, 171–192. [Google Scholar]
- Delaunay, J. The molecular basis of hereditary red cell membrane disorders. Blood Rev. 2007, 21, 1–20. [Google Scholar] [CrossRef]
- Moutzouri, A.G.; Skoutelis, A.T.; Gogos, C.A.; Missirlis, Y.F.; Athanassiou, G.M. Red blood cell deformability in patients with sepsis: A marker for prognosis and monitoring of severity. Clin. Hemorheol. Microcirc. 2007, 36, 291–299. [Google Scholar] [PubMed]
- Gyawali, P.; Richards, R.S.; Bwititi, P.T.; Nwose, E.U. Association of abnormal erythrocyte morphology with oxidative stress and inflammation in metabolic syndrome. Blood Cells Mol. Dis. 2015, 54, 360–363. [Google Scholar] [CrossRef]
- Karbiner, M.S.; Sierra, L.; Minahk, C.; Fonio, M.C.; Bruno, M.P.; Jerez, S. The role of oxidative stress in alterations of hematological parameters and inflammatory markers induced by early hypercholesterolemia. Life Sci. 2013, 93, 503–508. [Google Scholar] [CrossRef]
- Telen, M.J. Red blood cell surface adhesion molecules: Their possible roles in normal human physiology and disease. Semin. Hematol. 2000, 37, 130–142. [Google Scholar] [CrossRef]
- Lopes de Almeida, J.P.; Oliveira, S.; Saldanha, C. Erythrocyte as a biological sensor. Clin. Hemorheol. Microcirc. 2012, 51, 1–20. [Google Scholar] [CrossRef] [PubMed]
- Ciasca, G.; Papi, M.; Di Claudio, S.; Chiarpotto, M.; Palmieri, V.; Maulucci, G.; Nocca, G.; Rossi, C.; De Spirito, M. Mapping viscoelastic properties of healthy and pathological red blood cells at the nanoscale level. Nanoscale 2015, 7, 17030–17037. [Google Scholar] [CrossRef] [PubMed]
- Cho, Y.I.; Cho, D.J. Hemorheology and microvascular disorders. Korean Circ. J. 2011, 41, 287–295. [Google Scholar] [CrossRef]
- Gillespie, A.H.; Doctor, A. Red Blood Cell Contribution to Hemostasis. Front. Pediatr. 2021, 9, 629824. [Google Scholar] [CrossRef]
- Litvinov, R.I.; Weisel, J.W. Role of red blood cells in haemostasis and thrombosis. ISBT Sci. Ser. 2017, 12, 176–183. [Google Scholar] [CrossRef]
- Chung, S.M.; Bae, O.N.; Lim, K.M.; Noh, J.Y.; Lee, M.Y.; Jung, Y.S.; Chung, J.H. Lysophosphatidic acid induces thrombogenic activity through phosphatidylserine exposure and procoagulant microvesicle generation in human erythrocytes. Arterioscler. Thromb. Vasc. Biol. 2007, 27, 414–421. [Google Scholar] [CrossRef] [PubMed]
- Lim, H.W.G.; Wortis, M.; Mukhopadhyay, R. Stomatocyte-discocyte-echinocyte sequence of the human red blood cell: Evidence for the bilayer- couple hypothesis from membrane mechanics. Proc. Natl. Acad. Sci. USA 2002, 99, 16766–16769. [Google Scholar] [CrossRef]
- Pretorius, E.; Olumuyiwa-Akeredolu, O.O.; Mbotwe, S.; Bester, J. Erythrocytes and their role as health indicator: Using structure in a patient-orientated precision medicine approach. Blood Rev. 2016, 30, 263–274. [Google Scholar] [CrossRef]
- Gersh, K.C.; Nagaswami, C.; Weisel, J.W. Fibrin network structure and clot mechanical properties are altered by incorporation of erythrocytes. Thromb. Haemost. 2009, 102, 1169–1175. [Google Scholar] [CrossRef] [PubMed]
- Park, Y.; Best, C.A.; Badizadegan, K.; Dasari, R.R.; Feld, M.S.; Kuriabova, T.; Henle, M.L.; Levine, A.J.; Popescu, G. Measurement of red blood cell mechanics during morphological changes. Proc. Natl. Acad. Sci. USA 2010, 107, 6731–6736. [Google Scholar] [CrossRef] [PubMed]
- Tomaiuolo, G. Biomechanical properties of red blood cells in health and disease towards microfluidics. Biomicrofluidics 2014, 8, 051501. [Google Scholar] [CrossRef]
- Baier, D.M.T.; Mohr, T.; Windberger, U. Red Blood Cell Stiffness and Adhesion Are Species-Specific Properties Strongly Affected by Temperature and Medium Changes in Single Cell Force Spectroscopy. Molecules 2021, 26, 2771. [Google Scholar] [CrossRef] [PubMed]
- Diez-Silva, M.; Dao, M.; Han, J.; Lim, C.T.; Suresh, S. Shape and Biomechanical Characteristics of Human Red Blood Cells in Health and Disease. MRS Bull. 2010, 35, 382–388. [Google Scholar] [CrossRef] [PubMed]
- Olumuyiwa-Akeredolu, O.O.; Soma, P.; Buys, A.V.; Debusho, L.K.; Pretorius, E. Characterizing pathology in erythrocytes using morphological and biophysical membrane properties: Relation to impaired hemorheology and cardiovascular function in rheumatoid arthritis. Biochim. Biophys. Acta 2017, 1859, 2381–2391. [Google Scholar] [CrossRef]
- Benfante, A.; Scichilone, N. Prioritizing care for severe asthma during SARS-CoV-2 pandemic. Pulmonology 2021, 27, 189–190. [Google Scholar] [CrossRef]
- Liu, S.; Cao, Y.; Du, T.; Zhi, Y. Prevalence of Comorbid Asthma and Related Outcomes in COVID-19: A Systematic Review and Meta-Analysis. J. Allergy Clin. Immunol. Pract. 2021, 9, 693–701. [Google Scholar] [CrossRef]
- Kalemci, S.; Sarihan, A.; Zeybek, A. Does asthma affect outcomes of patients with COVID-19 infections? J. Allergy Clin. Immunol. Pract. 2021, 9, 594. [Google Scholar] [CrossRef]
- Heffler, E.; Detoraki, A.; Contoli, M.; Papi, A.; Paoletti, G.; Malipiero, G.; Brussino, L.; Crimi, C.; Morrone, D.; Padovani, M.; et al. COVID-19 in Severe Asthma Network in Italy (SANI) patients: Clinical features, impact of comorbidities and treatments. Allergy 2021, 76, 887–892. [Google Scholar] [CrossRef]

| Control | Asthma | |
|---|---|---|
| Age [Mean (range)] | 53 (17–55) | 45 (19–55) ns |
| Gender (M/F) | 19/11 | 9/21 |
| Medication (n) | ||
| Corticosteroids Immunosuppressant | - | 28 |
| Bronchodilator, Class I B2 adrenergic R antagonist | - | 19 |
| Bronchodilator, Class II B2 adrenergic R antagonist | - | 22 |
| Leukotriene receptor antagonist | - | 14 |
| Anti-histamine | - | 15 |
| Competitive nonselective phosphodiesterase inhibitor | - | 9 |
| Parameter | Normal Range | Control (n = 30) | Asthma (n = 30) | |||
|---|---|---|---|---|---|---|
| Mean | IQR Range | Mean | IQR Range | p Value | ||
| White Blood Cells | 3.92–9.88 | 6.46 | 5.99–7.09 | 7.14 | 5.41–8.38 | ns |
| Lymphocytes * 109 | 1–4 | 2.30 | 1.93–2.57 | 2.04 | 1.42–2.79 | ns |
| Monocytes * 109 | 0.18–1 | 0.36 | 0.24–0.42 | 0.69 | 0.29–0.96 | 0.0066 |
| Granulocytes * 109 | 2–7.5 | 3.81 | 3.52–4.01 | 4.43 | 2.92–5.64 | ns |
| Erythrocyte * 1012 | 4.7–6.1 | 4.72 | 4.42–5.02 | 5.72 | 4.79–6.41 | 0.0004 |
| Haemoglobin (g/dL) | 13.5–18 | 14.20 | 13.2–14.9 | 16.67 | 13.6–20.1 | 0.0057 |
| Haematocrit (%) | 38.8–50 | 41.75 | 38.5–44.9 | 48.68 | 40.6–57.0 | 0.0049 |
| Platelets * 109 | 150–450 | 237 | 193–265 | 192 | 107–278 | ns |
| Control | Asthma | |
|---|---|---|
| Mean Young’s Modulus | 46,711 | 50,760 ** |
| Standard Error | 749 | 896 |
| Median | 34,745 | 32,749 |
| Mode | 13,082 | 2689 |
| Standard Deviation | 39,211 | 56,216 |
| Sample Variance | 1,537,498,620 | 3,160,222,538 |
Disclaimer/Publisher’s Note: The statements, opinions and data contained in all publications are solely those of the individual author(s) and contributor(s) and not of MDPI and/or the editor(s). MDPI and/or the editor(s) disclaim responsibility for any injury to people or property resulting from any ideas, methods, instructions or products referred to in the content. |
© 2023 by the authors. Licensee MDPI, Basel, Switzerland. This article is an open access article distributed under the terms and conditions of the Creative Commons Attribution (CC BY) license (https://creativecommons.org/licenses/by/4.0/).
Share and Cite
Alummoottil, S.; van Rooy, M.J.; Bester, J.; Grobbelaar, C.; Phulukdaree, A. Scanning Electron and Atomic Force Microscopic Analysis of Erythrocytes in a Cohort of Atopic Asthma Patients—A Pilot Study. Hemato 2023, 4, 90-99. https://doi.org/10.3390/hemato4010009
Alummoottil S, van Rooy MJ, Bester J, Grobbelaar C, Phulukdaree A. Scanning Electron and Atomic Force Microscopic Analysis of Erythrocytes in a Cohort of Atopic Asthma Patients—A Pilot Study. Hemato. 2023; 4(1):90-99. https://doi.org/10.3390/hemato4010009
Chicago/Turabian StyleAlummoottil, Sajee, Mia J. van Rooy, Janette Bester, Craig Grobbelaar, and Alisa Phulukdaree. 2023. "Scanning Electron and Atomic Force Microscopic Analysis of Erythrocytes in a Cohort of Atopic Asthma Patients—A Pilot Study" Hemato 4, no. 1: 90-99. https://doi.org/10.3390/hemato4010009
APA StyleAlummoottil, S., van Rooy, M. J., Bester, J., Grobbelaar, C., & Phulukdaree, A. (2023). Scanning Electron and Atomic Force Microscopic Analysis of Erythrocytes in a Cohort of Atopic Asthma Patients—A Pilot Study. Hemato, 4(1), 90-99. https://doi.org/10.3390/hemato4010009

